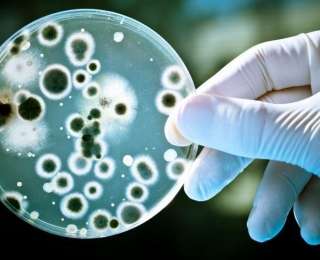

Мало кто знает, что грибок кандида не является опасным для нашего организма. В умеренном количестве он даже полезен, поскольку играет не последнюю роль в процессе пищеварения, помогая правильно усваивать питательные вещества.
Повышенный уровень условно-патогенного грибка в организме сопровождается такими симптомами: аллергия на некоторые продукты, беспричинная раздражительность, тяга к сладкому, вагинальные грибковые инфекции, усталость и головные боли.

Сегодня мы поговорим о кандидозе кишечника и научимся в домашних условиях делать тест на наличие условно-патогенных грибков в организме. Изначально грибок начинает размножаться в кишечнике, со временем перемещаясь в желудок, пищевод и полость рта.

В конечном результате человек, страдающий от кандидоза кишечника, обнаруживает у себя на языке белый плотный налет, который сложно убрать с помощью зубной щетки.
Тест на молочницу
В домашних условиях можно сделать тест на определение уровня грибка кандида в организме. Делать его следует с утра на голодный желудок. Подготовив прозрачный стакан с водой, необходимо собрать во рту немного слюны и плюнуть в него.

Если слюна спускается ко дну стакана тонкими ниточками, скорее всего у тебя проблемы с грибком кандида. В случае если слюна осталась плавать на поверхности, то уровень условно-патогенных грибков в организме находится в норме.


